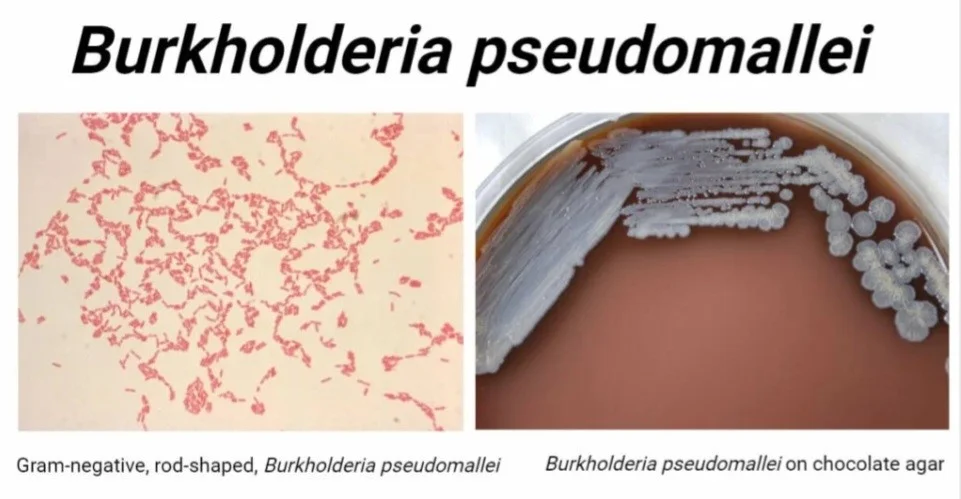
مورفولوژی بورخولدریا پسومالئی

مقدمهای بر بورخولدریا پسومالئی
بورخولدریا پسومالئی یک بتاپروتئوباکتری هوازی گرم منفی، متحرک، غیر اسپورساز و هوازی از شاخه Pseudomonadota در خانواده Burkholderiaceae است.
این یک باکتری ساپروفیت محیطی است که به طور طبیعی در خاک و آب یافت میشود. با این حال، B. Pseudomallei از باکتریهای خاک به باکتریهای پاتوژن داخل سلولی کشنده تبدیل شده که باعث ایجاد «ملیوئیدوز» در انسان میشود که حتی با تشخیص زودهنگام و درمان مناسب، میزان مرگ و میر آن بین 20 تا 40 درصد است.
این باکتری میتواند در شرایط سخت محیطی مانند درجه حرارت شدید، PH شدید، خاک خشک و شرایط کمبود مواد مغذی مانند آب مقطر برای چند روز زنده بماند و باعث بیماری کشنده شود. بنابراین به عنوان یک عامل Tier 1 select agent و سلاح زیستی توسط سازمانها فهرست شده است. CDC ایالات متحده (مرکز کنترل و پیشگیری از بیماری).
| قلمرو | Bacteria |
| راسته | Pseudomonadota |
| کلاس | Betaproteobacteria |
| طبقه | Burkholderiales |
| خانواده | Burkholdericeae |
| سرده | Burkholderia |
| گونه | B. pseudomallei |
زیستگاه بورخولدریا پسومالئی
- بورخولدریا پسومالئی باکتری خاک است. معمولاً در خاکهای مرطوب مناطق گرمسیری و نیمه گرمسیری یافت میشود. آنها در شالیزارهای برنج، مناطق باتلاقی و تالابها، خاکهای اطراف منابع آبی و حتی در آبهای راکد و آب رودخانهها دیده شدهاند.
- بورخولدریا پسومالئی میتواند انسان و حیواناتی مانند میمون، خوک، بز و گوسفند را آلوده کند و در بدن آنها زنده بماند.
مورفولوژی بورخولدریا پسومالئی
- این یک باکتری میلهای شکل گرم منفی است که در حدود 2 تا 5 میکرومتر طول و حدود 0.4 تا 0.8 میکرومتر عرض دارد.
- با رنگآمیزی دوقطبی ظاهر مشخصه آن زیر میکروسکوپ دیده میشود.
محیط کشت بورخولدریا پسومالئی
بورخولدریا پسومالئی یک باکتری غیر مستعد است و میتواند در محیطهای کشت متنوعی که برای سایر باکتریهای گرم منفی مانند MacConkey Agar، Blood Agar، Trypticase سویا آگار، Eosin Methylene Blue (EMB) Agar، Nutrient Agar استفاده می شود، رشد کند. با این حال، B. Pseudomallei به راحتی در سایر عوامل یا آلایندهها رشد میکند. بنابراین، همیشه لازم است از یک محیط انتخابی برای جداسازی Burkholderia pseudomallei استفاده شود.
محیط آشدون، محیط Burkholderia cepacia و Burkholderia pseudomallei agar انتخابی (BPSA) سه محیط انتخابی موجود هستند که به طور معمول در آزمایشگاههای میکروبیولوژی استفاده میشوند. در بین این سه محیط، محیط اشدون به دلیل گزینش پذیری سویههای B. Pseudomallei در نظر گرفته میشود. رشد سریع (پس از 18 تا 24 ساعت) در Burkholderia cepacia medium و BPSA قابل مشاهده است.
ویژگیهای محیط کشت بورخولدریا پسومالئی
در محیط اشدان، B. Pseudomallei پس از 48 ساعت انکوباسیون در دمای 37 تا 40 درجه سانتیگراد، کلنیهای بزرگ، چروکیده، دایرهای، مرطوب/موکوئیدی (در سویههای مخاطی) و خشک (در سویههای غیر موکوییدی) و خشک (در سویههای غیرمخاطی)، مسطح و ارغوانی ایجاد میکند. . این کلنیهای بنفش چروکدار شناسایی احتمالی B. Pseudomallei را تایید میکند.

در BPSA، مورفولوژی کلنی مشابه در کلنیهای بزرگ، چروکیده، دایرهای، مخاطی یا خشک، مسطح، ارغوانی/بنفش تا 48 ساعت دیده میشود و پس از انکوباسیون بیشتر در هوا در دمای 37 درجه سانتیگراد، به بنفش تیره تبدیل میشود.
در MacConkey آگار، کلنیهای بزرگ، صاف، صورتی، مرطوب/خشک پس از انکوباسیون یک شبه در دمای 37 درجه سانتیگراد دیده میشوند و این کلنیها پس از 2 روز انکوباسیون چروک میشوند.
در Blood Agar، کلنیها پس از 24 ساعت انکوباسیون هوازی در حدود 37 درجه سانتیگراد، کلنیهای بزرگ، صاف، کرمی، مرطوب/خشک خواهند بود و کلنیها در نهایت پس از 48 ساعت چروکیده میشوند.

ویژگیهای بیوشیمیایی بورخولدریا پسومالئی
آزمایشات بیوشیمی عمومی
| خصوصیات | Burkholderia pseudomallei |
| کپسول | اکثرا حاوی کپسولند و تعداد اندکی فاقد کپسول |
| کاتالاز | مثبت (+) |
| سیترات (Simmons) | متغیز {اکثرا در دمای انکوبهی زیر ۳۰درجه فاقد آن هستند } |
| فلاژلا | مثبت (+) |
| گاز | منفی (-) |
| رنگآمیزی گرم | باسیلهای گرم منفی
رنگ آمیزی دوقطبی ظاهر میلهای |
| H2S (Hydrogen Sulfide) | منفی (-) |
| ایندول | منفی (-) |
| تحرک | متحرک |
| Nitrate Reduction | مثبت (+) |
| اکسیداز | مثبت (+) |
| OF (Oxidative Fermentation) | هوازی |
| اسپور | منفی (-) |
| Triple Sugar Iron (TSI) | K/K (Alkaline/Alkaline) (Red/Red) |
| اورئاز | منفی (-) |
تست تخمیر کربوهیدرات
| خصوصیات | Burkholderia pseudomallei |
| آرابینوز | منفی (-) |
| آدیپیت | مثبت (+) |
| کاپرات | مثبت (+) |
| گلوکز | مثبت (+) |
| گلوکونات | مثبت (+) |
| لاکتوز | منفی (-) |
| مالتوز | منفی (-) |
| مالات | مثبت (+) |
| مانیتول | مثبت (+) |
| مانوز | مثبت (+) |
تست هیدرولاز
| خصوصیات | Burkholderia pseudomallei |
| مصرف استات | مثبت (+) |
| آرژنین دهیدرولاز | مثبت (+) |
| Aesculin Hydrolysis | منفی (-) |
| ژلاتیناز | مثبت (+) |
| PNPG | منفی (-) |
| ONPG (β-Galactosidase) | منفی (-) |
بیماریهای همراه بورخولدریا پسومالئی
بورخولدریا پسومالئی عامل بیماری کشنده انسانی “ملیوئیدوز” است. این بیماری عمدتاً در انسان و حیواناتی مانند خوک، بز و گوسفند دیده میشود. این بیماری با انتقال مستقیم باکتری از خاک یا آب به انسان از طریق بریدگیها یا زخمهای پوستی، بلعیدن یا استنشاق به انسان منتقل میشود.
انتقال فرد به فرد یا حیوان به فرد هنوز گزارش نشده است. میزان مرگ و میر ملیوئیدوز بسیار بالا است – حدود 20 تا 40٪ حتی با درمان. تخمین زده میشود که حدود 165000 نفر در سال به این بیماری مبتلا میشوند و 89000 نفر از آنها نمیتوانند زنده بمانند. (Limmathurotsakul D، Golding N، Dance DA، و همکاران، 2016)
بیشتر موارد در بیماران مبتلا به دیابت، مصرف بیش از حد الکل، عفونتهای مزمن ریه (فیبروز سیستیک و COPD)، بیماریهای مزمن کلیوی، فشار خون بالا و شرایط نقص ایمنی گزارش شده است. دیابت عامل خطر اصلی این بیماری است زیرا نزدیک به 40 درصد موارد ملیوئیدوز در بیماران دیابتی گزارش شده است.
تظاهرات بالینی متنوعی در ملیوئیدوز مشاهده شده که از تب خفیف و بثورات پوستی گرفته تا شرایط شدید مانند ذات الریه، باکتریمی، آبسه در اندامهای داخلی مانند کبد، طحال، کلیه و پروستات، شوک سپتیک، استئومیلیت، آرتریت سپتیک، حتی عفونت CNS در موارد نادر دیده میشود. موارد تظاهرات بالینی ملیوئیدوز شبیه سل است، بنابراین در بسیاری از مناطقی که ملیوئیدوز شایع نیست، این بیماری اغلب به اشتباه به عنوان سل تشخیص داده میشود. همچنین مواردی از ملوئیدوز با تشخیص اشتباه آسپرژیلوما بر اساس ضایعات حفرهای در عکسبرداری با اشعه ایکس قفسه سینه و سی تی اسکن نیز گزارش شده است.
عوامل بیماریزای بورخولدریا پسومالئی
بورخولدریا پسومالئی فاکتورهای حدت متعددی را نشان میدهند که به پاتوژنز بیماری کمک میکنند.
- کپسول و پیلی: هنگامی که باکتری در ابتدا به بدن میزبان میرسد، کپسول و پیلی به چسبندگی اولیه اپیتلیال یا مخاط کمک میکنند.
- فیمبریاها: فیمبریای نوع I در سطح خارجی باکتری وجود دارد و به چسبیدن با قندهای D-مانوسیله گلیکوپروتئینهای سطحی اپیتلیوم روده میزبان و ماکروفاژها کمک میکند.
- انتقالدهندهها: اینها پروتئینهای لنگر بر غشای خارجی هستند که به عنوان عامل چسبنده عمل کرده و به چسبندگی باکتریها و تهاجم به سلولهای ریه انسان کمک میکنند.
- لیپوپلی ساکارید (LPS): LPS، به ویژه جزء زنجیره پلیساکارید آنتیژن O (O-PS) LPS، پاسخ ایمنی میزبان را در مراحل اولیه عفونت سرکوب میکند.
- عوامل محافظت کننده از استرس اکسیداتیو مانند فاکتورهای سیگما، RpoS و RpoE، آنزیم کاتالاز-پراکسیداز I، سوپراکسید دیسموتاز، پروتئین اتصال دهنده DNA خانواده DPS فریتین و غیره برای محافظت در برابر گونههای فعال اکسیژن (ROS) سنتز میشوند.
- سیستمهای ترشح نوع III (T3SS): این T3SS به باکتریها کمک میکند تا از وزیکولهای اندوسیتی و فاگوزومها فرار کرده و وارد سیتوپلاسم میزبان شوند.
- سیستمهای ترشح نوع VI (T6SS): T6SS فاکتورهای بیماریزای مهمی هستند که به بقای باکتری، سمیت سلولی، تشکیل سلولهای غول پیکر چند هستهای (MNGC) و غیره کمک میکنند.
- فسفولیپازهای باکتریایی: این فسفولیپازها به بقای داخل سلولهای میزبان کمک میکنند، به تشکیل پلاک و ایجاد سمیت سلولی کمک میکنند.
- سموم: Pseudomallei قادر به ترشح سمی به نام Burkholderia Lethal Factor 1 (BLF1) است.
- پروتئین A Burkholderia Intracellular Motility A (BimA): پروتئین BimA به پلیمریزاسیون اکتین سلول میزبان کمک میکند. این پلیمریزاسیون دمهای اکتینی را تشکیل میدهد که توسط Pseudomallei برای حرکت خود در داخل سیتوپلاسم میزبان به سمت غشای سلول میزبان استفاده میشود.
- پمپهای خروجی: پمپهای خروجی در غشای خارجی خود نقش مهمی در مقاومت در برابر آنتیبیوتیکهایی مانند آمینوگلیکوزیدها، کولیستینها و ماکرولیدها دارند.

پاتوژنز بورخولدریا پسومالئی
بورخولدریا پسومالئی باکتریهای خاک و پاتوژنهای فرصت طلب هستند که عمدتاً از طریق خاک یا آب آلوده از 3 مسیر اصلی به میزبان انسان منتقل میشوند. انتقال از طریق تماس مستقیم با پوست حساس، بلع یا استنشاق.
پس از قرار گرفتن در معرض این عامل، به سلولهای میزبان متصل میشوند و با استفاده از کپسول، پیلی و چسبنده آنجا را احاطه میکنند. آنها شروع به حمله به سلولهای میزبان و فاگوسیتوز میکنند. آنها از مکانیسم کشتن در فاگوزومها و ماکروفاژها فرار می کنند و به سرعت با استفاده از طیف وسیعی از فاکتورهای حدت مانند T3SS به سیتوپلاسم می گریزند و در سیتوپلاسم تکثیر میشوند.
آنها الیاف اکتین میزبان را پلیمریزه میکنند تا دمهای اکتین را تشکیل دهند که خود را به سمت غشای سلول میزبان میبرند و MNGC را تشکیل داده و گسترش آنها را در بدن/بافت میزبان تسهیل میکند. این باعث آسیب به سلولهای میزبان میشود که توسط سموم و آنزیمهای سیتوتوکسیک ترشح شده توسط باکتری عفونی بدتر میشود.
اپیدمیولوژی بیماری بورخولدریا پسومالئی
ملیوئیدوز در استرالیای شمالی و کشورهای آسیایی مانند تایلند، ویتنام، مالزی، سنگاپور و مناطق جنوب شرقی آسیا مانند بخشهایی از هند و سریلانکا، جنوب چین، هنگ کنگ، تایوان و پاپوآ گینه نو بومی است. کشورهای دیگر نیز گهگاه موارد ملیوئیدوز را گزارش کردهاند.
تشخیص آزمایشگاهی و شناسایی بورخولدریا پسومالئی
جداسازی Burkholderia pseudomallei از محلهای آلوده، روش «استاندارد طلایی» برای تشخیص ملیوئیدوز است. در آزمایشگاه، چندین استراتژی شناسایی، بر اساس در دسترس بودن، برای شناسایی B. Pseudomallei اعمال میشود.
ویژگیهای کلنی و آزمایشهای بیوشیمیایی روشهای رایج و آسانی هستند که برای شناسایی B. Pseudomallei استفاده میشوند. برای تعیین مشخصات بیوشیمیایی، سیستم API 20NE با حساسیت و ویژگی حدود 99٪ مؤثرترین ابزار است. همچنین میتوان از سیستم خودکار Vitek 1 استفاده کرد.
تست آگلوتیناسیون لاتکس نیز برای شناسایی آسان و سریع آن موجود است.
الایزا با استفاده از آنتیژنهای OPS B. Pseudomallei یا سایر آنتیژنها برای تشخیص آنتیبادیها در سرم بیمار نیز در عمل برای بررسیهای اپیدمیولوژیک است.
تکنیکهای مولکولی مانند PCR، توالییابی ژن و بلات نسبت به سایر تکنیکهای شناسایی دقیق برتری دارند.
گزینههای درمانی و مقاومت آنتیبیوتیکی بورخولدریا پسومالئی
Burkholderia pseudomallei ذاتاً به پنی سیلین، آمپی سیلین، اغلب سفالوسپورینهای اولیه (نسل اول و دوم)، ماکرولیدها، ریفامایسینها، آمینوگلیکوزیدها (جنتامایسین) و کولیستین (پلی میکسینها) مقاوم است. این مقاومتها به دلیل چندین مکانیسم مقاومت آنتیبیوتیکی مانند نفوذناپذیری غشای باکتریایی، پمپ جریان، غیرفعال سازی آنزیمی، جداسازی داروها، اهداف آنتیبیوتیکی تغییر یافته، هیدرولیز آنزیمی و غیره است.
بورخولدریا پسومالئی به کوتریموکسازول، آموکسی سیلین-کلاوولانات، سفالوسپورینهای نسل سوم و جدیدتر، کارباپنمها، کلرامفنیکل، داکسی سایکلین، سفوپرازون-سولباکتام و غیره حساس است.
رژیم درمانی به دو مرحله تقسیم میشود. اولین مرحله فشرده که در آن آنتیبیوتیکهای IV تجویز میشود و سپس مرحله دوم که در آن آنتیبیوتیکهای خوراکی تجویز میشود. سفتازیدیم IV داروی انتخابی فعلی است. ایمی پنم، مروپنم، سفوپرازون-سولباکتام و آموکسی سیلین-کلاوولانات IV داروهای انتخابی در مرحله فشرده هستند. کوتریموکسازول داروی ارجح در مرحله ریشه کنی است. با این حال، انتخاب آنتیبیوتیک باید بر اساس تست حساسیت آنتیبیوتیکی و محل و مرحله عفونت انجام شود.
هیچ واکسنی علیه این باکتری ساخته نشده است. با این حال، کوتریموکسازول به عنوان یک داروی پیشگیری کننده در حین کار با باکتری در مناطق پرخطر یا پس از قرار گرفتن در معرض استفاده میشود.
همچنین بخوانید:
- EMB آگار: فرمول، اصول، آماده سازی، نتایج و موارد استفاده
- بلاد آگار: ترکیب، مراحل آمادهسازی، موارد استفاده
- مک کانکی آگار (MacConkey Agar): ترکیبات، اساس، کاربرد، تهیه و مورفولوژی کلنی
- اشدون آگار (Ashdown’s Agar): ترکیب، اصول، آمادهسازی، نتایج و کاربرد
- محیط کشت چیست؟ آشنایی با انواع محیط کشت و کاربرد
مترجم: شقایق مرتاضی



